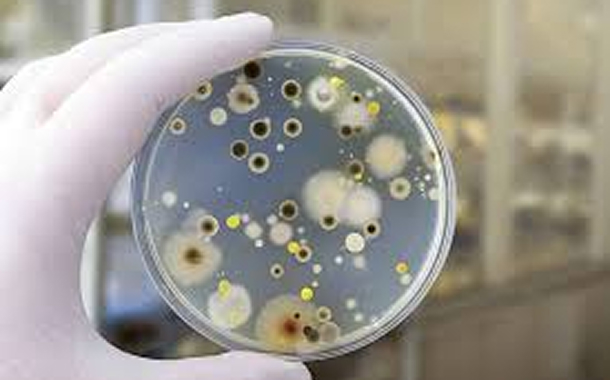

Asbestos exposure can cause serious health risks. Our licensed inspectors help identify materials that contain asbestos in your home or business with accurate lab results.
Our Lab Certified Services (Asbestos, Mold, Water, and more)
SERVICES
MOLD
Keep your health and your property intact with our mold testing and air quality analysis. We can help you identify any mold problems and keep your home safe.
RADON GAS
A leading cause of lung cancer among people who don’t smoke. You can trust our testing to assist with detecting any radon gas threat.
AIR QUALITY
Air quality can often be polluted with different contaminants and allergens. Our team can help you discover which of those are present in your home.
METH
Some properties may have hidden contamination left behind from former drug activity. We’re here to help make sure your home is safe by carefully inspecting and testing for any hazardous materials, giving you peace of mind for your family’s well-being.
VOC
Volatile Organic Compounds (VOCs) are gases from paints and building materials that can harm your health. We test for VOC levels and assess their risks to keep your space safe.
LEAD
Lead poisoning can be dangerous, especially for children. Our testing detects lead in water, paint or soil so you know your family is safe.
SERVICE DEEP - DIVE

ASBESTOS
In the 1980s, asbestos was used in a variety of construction materials and it now remains in a number of homes and buildings built back then. When materials that contain asbestos are disturbed or damaged fibres are released into the air and can cause serious lung diseases.
Whatever you’re planning to buy a home or do a renovation, asbestos testing should be one of your priorities. Our inspectors are AHERA certified and provide surveys and fast lab results so you can make an informed decision.
- Asbestos Testing
- Residential Asbestos
- Commercial Asbestos
MOLD
Having mold in your home can cause allergies, asthma and many other respiratory issues. It doesn’t only pose issues for your health, but your home too. When mold is hidden behind walls or under floors, it can spread before you even notice it. We do testing to identify what type of mold is present in your home or business, as well as what concentration of it is there.
Services:
- Mold Testing & Inspection
- Residential Mold Assessment
- Commercial Mold Analysis

RADON GAS
Radon is a radioactive gas. When breathed in, it gets into the lining of your lungs and gives off radiation. That exposure can damage cells and lead to lung cancer over time. Radon is the second largest cause of lung cancer after smoking. Our lab testing is the only reliable way to determine your level of radon exposure.. We offer professional radon testing services with appropriate equipment that can measure radon concentration accurately.
Services:
- Radon Testing
- Residential Radon Monitoring
- Commercial Radon Screening

AIR QUALITY
When your air quality is questionable, it can affect your productivity and quality in life. Dust, pet dander and ventilation problems can all compromise the air you breathe. With our testing, we can analyze for different particles and humidity levels to give you the exact assessment of your indoor environment.
Services:
- Indoor Air Quality Testing
- Residential Air Quality Assessment
- Commercial Air Quality Analysis

METH
Residue from meth in your house or business can pose serious risks and long term health issues. Exposure can cause skin irritation, respiratory problems, dizziness, headache and developmental issues in children. Testing your home or business is important and we provide meth testing, to give you the insight you need in order to feel safe wherever you are.
Services:
- Meth Contamination Testing
- Residential Meth Lab Screening
- Commercial Property Testing

VOC
Volatile organic compounds are chemicals that evaporate at room temperature. They come from paints, cleaners and furnishings. Some VOCs can cause eye, nose and throat irritation. They can also cause kidney and liver issues as well as problems with your nervous system. We will help identify any kind of damaging VOCs in your environment and help you make steps to improve your indoor air quality.
Services:
- VOC Testing & Analysis
- Residential VOC Screening
- Commercial VOC Assessment

LEAD
Exposure to lead can be very dangerous for children and their brains during development, but it’s risky for adults too. Although it was banned in paint in the late 1970s, it can still be found in many older homes. Our lead testing will help you with identification of lead in paint, dust, water and soil.
Services:
- Lead Testing & Inspection
- Residential Lead Assessment
- Commercial Lead Screening
Health & Safety Information
WHY TEST? - RISKS & CONCERNS
Asbestos Health Risks
One of the most serious environmental health hazards is Asbestos. When the fibers of asbestos are inhaled they become lodged in the lung tissue. This can lead to many different issues like lung cancer, mesothelioma, asbestosis, and pleural thickening.
Radon Health Risks
Radon is the number one cause of lung cancer among non-smokers, according to the EPA. This radioactive gas is colorless and odorless, and can enter buildings through cracks in foundations and pipes. Children can also be more susceptible to radon because they breathe at a faster pace.
Mold Health Risks
Though mold sometimes seems like it can lead to mild risks like allergic reactions such as sneezing and skin rashes, it can also cause serious respiratory problems and asthma attacks.
Mold has a musty, earthy smell and unchecked mold can grow so testing for it can help with maintenance of air quality.
Lead Health Risks
Both children and adults can suffer from lead exposure. Adults can suffer from reproductive problems, high blood pressure and hypertension, nerve disorders, muscle and joint pain. Effects of lead on children are lowered IQ, damage to the brain and nervous system, learning and behavioral difficulties, slowed growth and hearing problems. There is no safe blood lead level for children. Testing for lead in your spaces is the most effective way to know what kind of exposure exists.
Methamphetamine Health Risks
Meth production leaves behind toxic chemical residues that can linger on surfaces, carpets, and in ventilation systems. Exposure to these contaminants can cause respiratory problems, headaches, nausea, and dizziness. Because children are especially vulnerable, testing your space is essential to ensure it’s safe and free from harmful substances.
VOC Health risks
Exposure to VOC can be short-term and cause eye, nose and throat irritation, while long-term exposure can lead to liver and kidney damage as well as increased cancer risk with certain types of VOCs. These compounds are often invisible and odorless, even at harmful levels, which is why testing is essential to understand your VOC exposure.
Poor Air Quality Risks
Though it may seem like less of a concern when compared to lead and meth residue, poor indoor air quality can also contribute to health issues such as allergies and asthma. Americans spend 90% of their time indoors, so keeping the air healthy is invaluable. Air can contain many different pollutants at various levels, that come from high humidity, allergens from pets and dust so checking for these pollutants creates a roadmap to a healthier indoor life.



